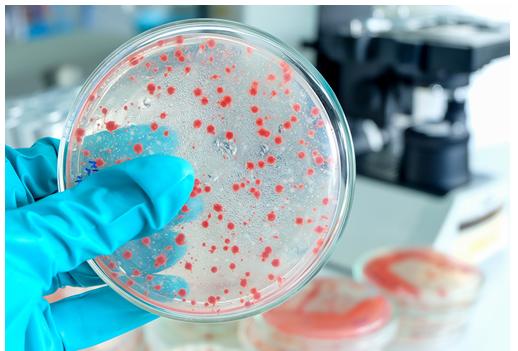
Bacteriological Testing Market

Press release
Bacteriological Testing Market Soars: Key Trends, Innovations, and Growth Opportunities 2025-2032 | Major players - Erber Group, Lamotte company, Bureau veritas, Intertek group plc.
Market Overview:The Global Bacteriological Testing Market is estimated to reach at a CAGR of 7.9% during the forecast period 2024-2031.
The Bacteriological Testing Market refers to the global industry focused on detecting, identifying, and analyzing bacterial contamination in food, water, pharmaceuticals, and clinical samples. It involves advanced testing methods, including culture-based, molecular, and immunological techniques, to ensure safety, quality, and regulatory compliance. Rising demand for food safety, healthcare diagnostics, and environmental monitoring drives market growth.
Get a Free Sample PDF Of This Report (Get Higher Priority for Corporate Email ID): https://datamintelligence.com/download-sample/bacteriological-testing-market?sz
(Single User Report: USD 3480 & One Year Database Subscription: USD 10K)
Recent Key Developments of United States:
✅ December 2025: Investments in AI-driven bacteriological analysis expanded, improving accuracy in pharmaceutical sterility testing nationwide.
✅ November 2025: US advancements in portable PCR devices gained traction for on-site bacteriological testing, enhancing food safety protocols in processing plants.
✅ October 2025: The FDA approved a rapid PCR-based testing kit from a leading US biotech firm, cutting Salmonella detection time from 48 hours to under 4 hours for poultry processors. This supports stricter USDA compliance amid rising demand for ready-to-eat foods.
Recent Key Developments of Japan:
✅ January 2026: Japan's biopharma sector advanced serum-free bacterial culture media adoption, boosting R&D for industrial testing applications.
✅ December 2025: A Tokyo-based firm launched biosensor technology for on-site Norovirus screening in convenience stores, integrated with government apps for instant reporting.
✅ November 2025: Yano Research Institute noted widespread adoption of portable immunoassay kits by sushi manufacturers, reducing Campylobacter testing costs by 30% to meet US export standards.
List of the Key Players in the Bacteriological Testing Market:
Erber Group
Rakiro biotech systems pvt. Ltd
Acmas technologies (p) ltd
Lamotte company
EMSL analytical, inc.
ATCC
Northeast laboratory services
SGS SA
Bureau veritas
Intertek group plc
CSA group
Bruker
bioMérieux SA
Speak to Our Analyst and Get Customization in the report as per your requirements: https://datamintelligence.com/customize/bacteriological-testing-market?sz
(Single User Report: USD 3480 & One Year Database Subscription: USD 10K)
This Report Covers:
✔ Go-to-market Strategy.
✔ Neutral perspective on the market performance.
✔Development trends, competitive landscape analysis, supply side analysis, demand side analysis, year-on-year growth, competitive benchmarking, vendor identification, and other significant analysis, as well as development status.
✔Customized regional/country reports as per request and country level analysis.
✔ Potential & niche segments and regions exhibiting promising growth covered.
✔ Analysis of Market Size (historical and forecast), Total Addressable Market (TAM), Serviceable Available Market (SAM), Serviceable Obtainable Market (SOM), Market Growth, Technological Trends, Market Share, Market Dynamics, Competitive Landscape and Major Players (Innovators, Start-ups, Laggard, and Pioneer).
Segments Covered in the Bacteriological Testing Market:
By Bacteria: Shigella, Coliform, Cellulitis, Legionella, Meningitis, Helicobacter pylori, Others.
By Technology: Rapid, Polymerase Chain Reaction (PCR), Spectrometry, Enzyme-Linked Immunosorbent Assay, Others, Traditional.
By Component: Test Kits, Instruments, Consumables & Reagents.
By End-User: Food & Beverage, Meat & Poultry, Dairy, Fruits & Vegetables, Cereals & Grains, Others, Water, Pharmaceuticals, Cosmetics, Others.
Regional Analysis:
⇥ North America (U.S., Canada, Mexico)
⇥ Europe (U.K., Italy, Germany, Russia, France, Spain, The Netherlands and Rest of Europe)
⇥ Asia-Pacific (India, Japan, China, South Korea, Australia, Indonesia Rest of Asia Pacific)
⇥ South America (Colombia, Brazil, Argentina, Rest of South America)
⇥ Middle East & Africa (Saudi Arabia, U.A.E., South Africa, Rest of Middle East & Africa)
Looking For Full Report? Get it Here: https://www.datamintelligence.com/buy-now-page?report=bacteriological-testing-market
Chapter Outline
⏩ Market Overview: It contains five chapters, as well as information about the research scope, major manufacturers covered, market segments, Bacteriological Testing market segments, study objectives, and years considered.
⏩ Market Landscape: The competition in the Global Bacteriological Testing Market is evaluated here in terms of value, turnover, revenues, and market share by organization, as well as market rate, competitive landscape, and recent developments, transaction, growth, sale, and market shares of top companies.
⏩ Companies Profiles: The Global Bacteriological Testing market's leading players are studied based on sales, main products, gross profit margin, revenue, price, and growth production.
⏩ Market Outlook by Region: The report goes through gross margin, sales, income, supply, market share, CAGR, and market size by region in this segment. North America, Europe, Asia Pacific, Middle East & Africa, and South America are among the regions and countries studied in depth in this study.
⏩ Market Segments: It contains the deep research study which interprets how different end-user/application/type segments contribute to the Bacteriological Testing Market.
⏩ Market Forecast: Production Side: In this part of the report, the authors have focused on production and production value forecast, key producers forecast, and production and production value forecast by type.
⏩ Research Findings: This section of the report showcases the findings and analysis of the report.
⏩ Conclusion: This portion of the report is the last section of the report where the conclusion of the research study is provided.
Unlock 360° Market Intelligence with DataM Subscription Services: https://www.datamintelligence.com/reports-subscription
People Also Ask:
◆ How big is the Bacteriological Testing Market in 2025?
◆ What is the projected growth rate of the Bacteriological Testing Market through 2033?
◆ Who are the key players in the Bacteriological Testing Market?
◆ Which region is expected to dominate the industry during the forecast period?
Contact Us -
Company Name: DataM Intelligence
Contact Person: Sai Kiran
Email: Sai.k@datamintelligence.com
Phone: +1 877 441 4866
Website: https://www.datamintelligence.com
About Us -
DataM Intelligence is a Market Research and Consulting firm that provides end-to-end business solutions to organizations from Research to Consulting. We, at DataM Intelligence, leverage our top trademark trends, insights and developments to emancipate swift and astute solutions to clients like you. We encompass a multitude of syndicate reports and customized reports with a robust methodology.
Our research database features countless statistics and in-depth analyses across a wide range of 6300+ reports in 40+ domains creating business solutions for more than 200+ companies across 50+ countries; catering to the key business research needs that influence the growth trajectory of our vast clientele.
This release was published on openPR.
Permanent link to this press release:
Copy
Please set a link in the press area of your homepage to this press release on openPR. openPR disclaims liability for any content contained in this release.
You can edit or delete your press release Bacteriological Testing Market Soars: Key Trends, Innovations, and Growth Opportunities 2025-2032 | Major players - Erber Group, Lamotte company, Bureau veritas, Intertek group plc. here
News-ID: 4366219 • Views: …
More Releases from DataM Intelligence 4Market Research
Luxury Vinyl Tiles Market Soars: Trends, Growth Drivers, and Future Opportunitie …
Market Overview:
The Global Luxury Vinyl Tiles Market is estimated to reach at a CAGR of 11.2% during the forecast period (2024-2031).
The Luxury Vinyl Tiles (LVT) Market encompasses the production, distribution, and sale of high-quality, durable flooring solutions that mimic natural materials like wood and stone. LVT is favored for its aesthetic appeal, water resistance, and ease of maintenance, finding extensive applications in residential, commercial, and hospitality sectors worldwide. Growing urbanization…
Regulatory Compliance Market is projected to reach USD 32.61 billion by 2033 | M …
Market Size and Growth:
The Global Regulatory Compliance Market size reached USD 19.24 billion in 2024 and is projected to reach USD 32.61 billion by 2033, growing at a CAGR of 6.02% during the forecast period 2025 to 2033.
The Regulatory Compliance Market encompasses products and services that help organizations adhere to laws, standards, and industry regulations. It includes software, consulting, and auditing solutions designed to manage risk, ensure legal conformity, and…
Biofuel Enzymes Market Set to Soar: Innovations Driving Cleaner, Efficient Energ …
Market Overview:
The Global Biofuel Enzymes Market is estimated to grow at a CAGR of 6.4% during the forecast period 2024-2031.
The Biofuel Enzymes Market refers to the global industry involved in the production and commercialization of enzymes that accelerate the conversion of biomass into biofuels, such as ethanol and biodiesel. These enzymes enhance efficiency, reduce costs, and support sustainable energy solutions. Growth is driven by increasing demand for renewable fuels, technological…
Green Hydrogen Market Soars: Innovations, Investments, and Global Growth Trends …
Market Overview:
The Global Green Hydrogen Market is expected to reach at a CAGR of 20.9% during the forecast period (2024-2031).
The Green Hydrogen Market encompasses the production, distribution, and application of hydrogen generated through renewable energy sources, such as wind, solar, and hydropower, using water electrolysis. It serves industries like transportation, power generation, and chemicals, aiming to reduce carbon emissions and support sustainable energy transitions. Market growth is driven by decarbonization…
More Releases for Test
Key Differences Between Megger Test, Tan Delta Test, and Hi-Pot Test for Electri …
Electrical insulation plays a critical role in ensuring the safety and efficiency of electrical systems. To assess the condition of insulation and identify potential issues, three common tests are used: the Megger test, Tan Delta test, and Hi-Pot test. Each test serves a unique purpose and provides valuable insights into the state of electrical insulation. Here's a closer look at the differences between these three essential tests.
Megger Test: Insulation Resistance…
Vitamin Test Market: Global Vitamin Test Analysis and Forecast (2023-2029)Vitami …
12.04.2024: Vitamin Test Market Overview
The development of companion diagnostic tools and advances in personalised treatment are driving considerable growth and revolution in the oncology Vitamin Test market. In the era of precision medicine, where healthcare is increasingly customised for individual individuals based on their own genetic and molecular profiles, this market segment is essential. Ongoing innovation and development define the oncology Vitamin Test market. To find particular biomarkers, genetic mutations,…
CAGR 8.1% Homecare Pregnancy Test Kits Market By Type of Test (Urine Test For H …
The Homecare Pregnancy Test Kits market report by Reports and Data provides an extensive overview of the vital elements of the Homecare Pregnancy Test Kits market and factors such as the drivers, restraints, latest trends, supervisory scenario, competitive landscape, technological advancements, and others. Further, it mentions the market shares associated with the market in terms of both value and volume along with the segmentation. Space-age industrial and digitalization tools are…
Home Safety Test Kits Market, Home Safety Test Kits Market Trends, Home Safety T …
“Home Safety Test Kits Market” 2020-2025 Research Report is a professional and in-depth study on the current state of the market. Global Home Safety Test Kits market containing a complete view of the market size, business share, profit estimates, SWOT analysis and the regional landscape of the Industry. The report explains key challenges and future development prospects of the market. The Global Home Safety Test Kits analysis is provided for…
Test Data Management (TDM) Market - test data profiling, test data planning, tes …
The report categorizes the global Test Data Management (TDM) market by top players/brands, region, type, end user, market status, competition landscape, market share, growth rate, future trends, market drivers, opportunities and challenges, sales channels and distributors.
This report studies the global market size of Test Data Management (TDM) in key regions like North America, Europe, Asia Pacific, Central & South America and Middle East & Africa, focuses on the consumption…
Hearing Screening and Diagnostic Devices Market Demands with Major Tests: pure T …
New Market Research Reports Title "Hearing Screening And Diagnostic Devices Market 2018" Has Been Added to Crystal Market Research Report database.
Hearing Screening and Diagnostic Devices - Competitive Insights:
The leading players in the market are Gn Otometrics A/S, Otodynamics, Nashua Hearing Group, Siemens Healthineers, Natus Medical Incorporated, Interacoustics A/S, Neurosoft S.A, Accent Hearing Pty Ltd, MAICO Diagnostics GmbH and IntriCon Corporation. The major players in the market are profiled in detail…